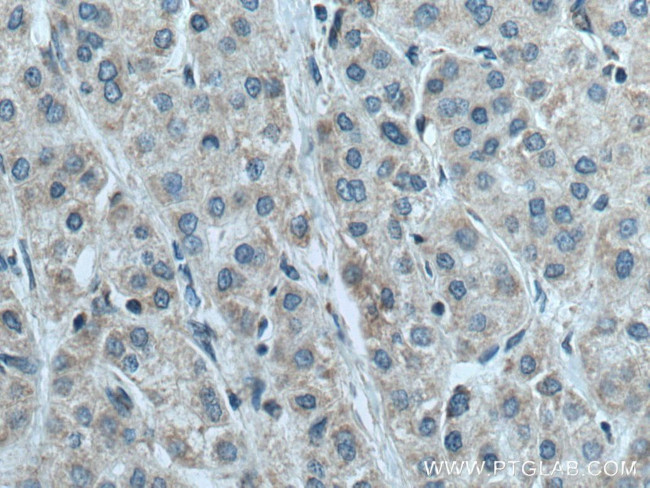
NDUFB6 Antibody in Immunohistochemistry (Paraffin) (IHC (P))

Search
Proteintech
NDUFB6 Polyclonal Antibody
{{$productOrderCtrl.translations['antibody.pdp.commerceCard.promotion.promotions']}}
{{$productOrderCtrl.translations['antibody.pdp.commerceCard.promotion.viewpromo']}}
{{$productOrderCtrl.translations['antibody.pdp.commerceCard.promotion.promocode']}}: {{promo.promoCode}} {{promo.promoTitle}} {{promo.promoDescription}}. {{$productOrderCtrl.translations['antibody.pdp.commerceCard.promotion.learnmore']}}
产品信息
16037-1-AP
种属反应
已发表种属
宿主/亚型
分类
类型
抗原
偶联物
形式
浓度
规格
纯化类型
保存液
内含物
保存条件
运输条件
产品详细信息
Immunogen sequence: MTGYTPDEK LRLQQLRELR RRWLKDQELS PREPVLPPQK MGPMEKFWNK FLENKSPWRK MVHGVYKKSI FVFTHVLVPV WIIHYYMKYH VSEKPYGIVE KKSRIFPGDT ILETGEVIPP MKEFPDQHH (1-128 aa encoded by BC009801 )
靶标信息
Methylation of cytosine at CpG dinucleotides is a common feature of many higher eukaryotic genomes. Increasing evidence indicates that recruitement of histone deacetylase complexes by methyl-CpG-binding proteins (MeCP) is a major mechanism of methylated DNA silencing. P66, a zinc finger-containing protein is one of the components of the MeCP1 complex. P66 and p68, the two components of MeCP1 are different forms of the same zinc finger-containing protein and are conserved from C.elegans to humans. Homologs of p66 from different organisms revealed two highly conserved regions, CR1 and CR2. While CR1 is involved in the association of p66 with other MeCP1 components, CR2 plays an important role in targeting p66 and MBD3 to specific loci.
仅用于科研。不用于诊断过程。未经明确授权不得转售。
生物信息学
蛋白别名: CI-B17; complex I, mitochondrial respiratory chain, B17 subunit; Complex I-B17; NADH dehydrogenase (ubiquinone) 1 beta subcomplex, 6, 17kDa; NADH dehydrogenase [ubiquinone] 1 beta subcomplex subunit 6; NADH-ubiquinone oxidoreductase B17 subunit; NADH-ubiquinone oxidoreductase beta subunit, 6; NDUFB6; unnamed protein product
基因别名: B17; CI; Gm137; NDUFB6
UniProt ID: (Human) O95139, (Mouse) Q3UIU2
Entrez Gene ID: (Human) 4712, (Rat) 297990, (Mouse) 230075